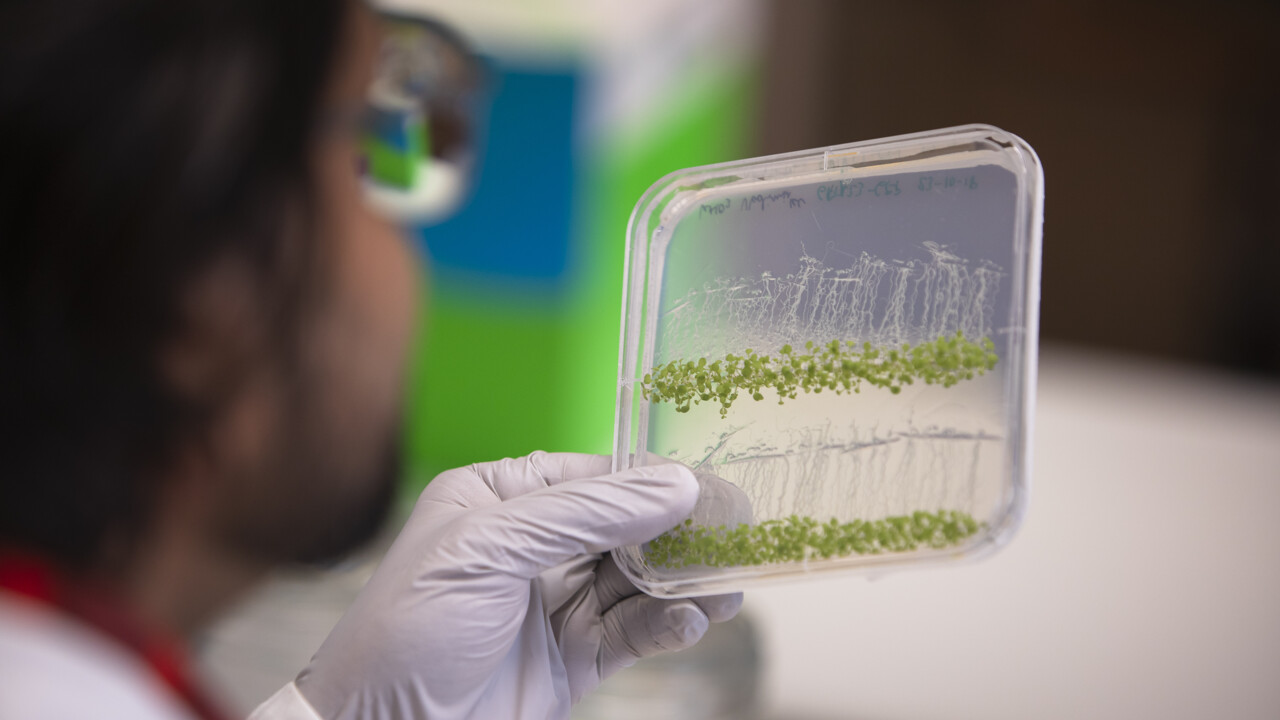
Dhruv Agrawal

Korta fakta om Dhruv
Kommer från: Indien
Jag med tre ord: passionerad, enkel och organiserad
Intressen: Musik, rita och kolla på film
Favoritbok: Wallflower av av Stephen Chbosky
Streamar: Biopics (filmer som gestaltar personers liv)
Lyssnar på: Countrymusik
Saknar hemifrån: Gatumat från de lokala försäljarna
Det första svenska ordet jag lärde mig: Vatten
På min bucket list: Lära mig att dyka
Favorit semesterplats: Sommarkväll på stranden
Tycker om att: laga mat och det gör mig ledsen när jag ser mat gå till spillo